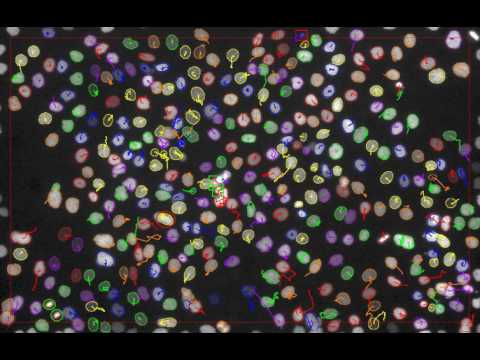

S. U. Akram, J. Kannala, L. Eklund & J. Heikkilä,
The paper can be found at arXiv and cell proposal network code is available at github. If you find this code useful in your research, please consider citing:
@article{akram2017a,
author = {Akram S. U., Kannala J., Eklund L., and Heikkilä J.},
title = {Cell Tracking via Proposal Generation and Selection},
journal = {arXiv:1705.03386},
year = {2017}
}
The code has many half finished and broken features, which i plan to either remove or fix in the future. The code was re-structred recently and it may have introduced some bugs, which you may report (especially if they are in parts which are executed) and i will try to fix them. If and when i fix this code, i may remove the experimental exp branch.
- CPN: Cell Proposal Network code.
git clone https://github.com/SaadUllahAkram/CPN.git - CellTracker: Cell Tracking code.
git clone https://github.com/SaadUllahAkram/CellTracker.git - caffe: Faster R-CNN version with crop layer.
git clone https://github.com/SaadUllahAkram/caffe_cpn.git - BIA: a collection of useful functions.
git clone https://github.com/SaadUllahAkram/BIA.git - MATLAB
- Gurobi
- Set
Gurobi, Caffe, ISBI CTC datapaths inget_paths.mfunction in BIA: - activate caffe using:
bia.caffe.activate('cpn', gpu_id); - Download Cell Tracking Challenge data.
- run
demo_test_tracker()
- run
demo_train_tracker()
Trained models and demo will be added soon.
Videos show the boundaries of cells within the field of interest.
Color of cell boundaries identifies the track identity and color of each track remains same for the whole sequence.
Field of interest, the region inside which cells are tracked, is highlighted with the red rectangle.
Cell events are highlighted: enter (green boxes), leave (red boxes), mitosis (red circle) and daughter cells (green circle).